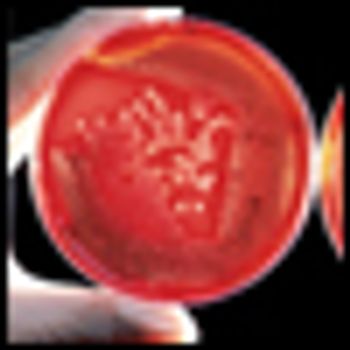

One in 3 nurses do not feel emotionally health, a large number of whom have experienced trauma due to the COVID-19 pandemic and no longer wish to be in their job position.

Your AI-Trained Oncology Knowledge Connection!


One in 3 nurses do not feel emotionally health, a large number of whom have experienced trauma due to the COVID-19 pandemic and no longer wish to be in their job position.

Investigators have identified a gap in end-of-life care among patients with cancer who are dual eligible for Medicare and Medicaid.

The THRIVE Program includes an 8-hour retreat designed to teach staff skills for combating compassion fatigue and for promoting resilience.

In an interview with Cancer Network, Lorraine Drapek describes a multidisciplinary program at MGH to support vaginal and sexual health post RT for GI and gynecologic malignancies.

Oncology nurse leaders share insights into the care of vulnerable oncology populations-from ED triage to tailored telehealth sessions for homeless populations.

A pilot protocol developed at Memorial Sloan Kettering Cancer Center resulted in exponential increases in both influenza and pneumococcal vaccinations in the outpatient setting.

Oncology nursing leader Deborah Boyle highlights some essential tips to address common issues in bedside care, staff communication, and on-the-job distress.

Alisa Domb highlighted training and workflow optimization for an ambulatory-setting navigation program covering 10 hem/onc clinics and 2 cancer centers, during the 2018 ONS Congress.

Jeannine Brant, PhD, APRN-CNS, discussed the importance of using non-opioid modalities to manage cancer patients' pain, during the 2018 ONS Congress.

Updates to the 8th edition of AJCC's staging manual include incorporation of more nonanatomic features. Oncology Clinical Specialist Chelsea Backler discussed key changes during the 2018 ONS Congress.

Detailed education and other initiatives related to CHG cloth use boosted bathing compliance rates by 95% in 14 months, and decreased CLABSI by 8%.

After non-oncology units received comprehensive safety kits for handling oral hazardous drugs, chemo handling precautions at Maine Medical Center increased significantly.

As an oncology health care provider, it is crucially important to process grief and loss in order to best care for yourself and your patients.

The needs and challenges of cancer survivors and their family members do not vanish once treatment has been completed, although their follow-up care is often not addressed sufficiently.

When we do too much for patients, we can unintentionally reinforce their sense of not being able to address their own needs. Reinforcing patients' responsibility for their own healthcare care can result in an improved sense of empowerment and control.

Mood disorders are common mental health sequelae of cancer, but depression in patients with cancer is frequently missed by healthcare providers, and there are many reasons for this oversight.

Aprepitant plus palonosetron and dexamethasone showed early promise for preventing chemotherapy-induced nausea and vomiting among patients with colorectal cancer who are undergoing FOLFOX chemotherapy, according to results of a small pilot study.

Comprehensive geriatric assessments will play an increasingly important role in identifying patient frailty and personalizing geriatric oncology treatment, according to recently published reviews.

Brief training can improve the effective communication of bad news to patients with cancer, according to a recently published randomized controlled trial and a separate evidence-based review.

Adherence to antiemetic regimens for patients undergoing emetogenic cancer chemotherapy is poor, according to an online survey of oncology nurses in the United States.

Follow-up intervention by patient navigators or provider reminders may help to improve the number of patients who undergo colonoscopy after positive fecal blood test results.

It is increasingly important that nurses recognize cytokine release syndrome and other side effects that can be triggered by treatment with engineered CAR T-cell therapies.

In this interview we discuss a study that looked at the effect of an 8-week exercise intervention on treatment side effects for patients with prostate cancer.

Oncology nurses and others should pay close attention to their patients’ quality-of-life concerns, but what that means will vary from patient to patient.

Chlorhexidine wipe bathing might help reduce the risk of deadly central line-associated bloodstream infections (CLABSIs) among cancer inpatients, but barriers can complicate implementation efforts.

In this interview we discuss pain management for cancer patients who are at high risk of opioid abuse.

In this interview we discuss how obesity can affect cancer treatment, and how healthcare providers can better communicate with overweight patients on issues such as diet and exercise.

In this interview we discuss follow-up care and screening for second primary cancers in cancer survivors.

Patients with moderate cancer pain report significantly greater pain relief after taking low-lose morphine as opposed to weaker opioids.

As the lead caregiver at the bedside, the oncology nurse plays a pivotal role in preventing missteps in end-of-life care decisions and ensuring that providers carry out the wishes of patients and families.

Identifying breast cancer patients who are at low risk for chemotherapy-induced nausea and vomiting before the start of treatment may help avoid unnecessary use of antiemetic medications without compromising quality of care.

A drug commonly given to cancer patients to relieve opioid-induced constipation is capable of slowing tumor growth and may play a role in developing new drug therapies.

Palliative care should be provided with cancer care early in the course of illness for all patients with advanced disease, according to a new guidance statement from ASCO and the American Academy of Hospice and Palliative Medicine.

A simple one-question tool may help oncologists more accurately predict cancer patients’ prognoses and know when to initiate end-of-life discussions.

By introducing a patient-centric navigation system, researchers were able to provide treatment recommendations to the majority of patients with head and neck cancer within a 2-week period.

Oncology and advanced practice nurses are key players in developing and managing specialized clinics that combine geriatrics and oncology care, according to a recent study.

Modifying pain intensity scales to include frequency as well as intensity of pain may be a more accurate and efficient way of screening cancer patients for pain.

The US Food and Drug Administration has approved rolapitant for the prevention of delayed phase nausea and vomiting associated with chemotherapy.

Cancer survivors who were diagnosed as teens often experience emotional distress and neurocognitive dysfunction, interfering with social development as adults.

Cancer survivors may face discrimination by adoption agencies, many of which require medical histories and statements of health to be shared with birth mothers.

In this video from the 2015 ONS meeting, Dr. Sipples talks about effective management of side effects for patients taking afatinib, an oral, targeted agent for lung cancer.

In this video from the 2015 ONS meeting, Dr. Omran discusses the high-risk of colorectal cancer among the Jordanian population and the need to promote more screening awareness.

In this video from the 2015 ONS meeting, Dr. Gwyn talks about nurse practitioners delivering bad news to patients by utilizing the SPIKES protocol.

The topic of obesity and its effect on cancer risk and subsequent treatment was discussed in detail at this year's Oncology Nursing Society annual meeting in Orlando, Florida.

Patients with lung cancer are increasingly receiving targeted therapies that induce complete disease remissions, but they can also develop resistance to these drugs. New efforts are now underway to discover and develop new options for patients experiencing drug resistance.

Results of a single-institution study found the risk for fracture among survivors of hematopoietic stem-cell transplantation increased by nearly eight times.

Patients with lung and colorectal cancer who understood that chemotherapy would not cure them were no less likely to receive chemotherapy at the end of life.

Many women with breast cancer do not understand the details of their tumor characteristics or how they relate to specific treatment options, according to a new study.

Group exercise programs can improve the physical and mental well-being of prostate cancer patients, as well as providing emotional and social support.

ONS has released a position paper on palliative care, emphasizing its importance throughout cancer treatment and the critical role of nurses.

Risk for febrile neutropenia was high among patients with metastases from a variety of common cancers and was associated with numerous clinical and economic consequences, including increased morbidity and mortality.

A large trial showed that treatment-emergent vasomotor and/or joint symptoms do not correlate with any improvement in recurrence-free survival in postmenopausal breast cancer patients treated with aromatase inhibitors.

Data from the Women’s Intervention Nutrition Study found a reduction in dietary fat intake resulted in lower death rates in ER- and PR-negative breast cancer.

Researchers have developed a screening tool to help oncology providers identify cancer patients who may benefit from referral to a palliative care specialist.

Cancer patients who received hospice care during the last year of life had fewer hospitalizations and lower overall costs than patients outside of hospice.

As part of our Society of Neuro-Oncology annual meeting coverage, we discuss quality of life issues and neurologic rehabilitation in patients with neuro-oncologic diseases.

More than twice as many cancer survivors at risk for cardiomyopathy underwent screening for the condition when exposed to advanced-practice nurse telephone counseling.

Nurses trained in the visual inspection with acetic acid cervical cancer screening method were able to successfully perform colposcopy and detect cervical lesions.

A phone-based symptom monitoring system using "smart technology" led to improvements in patient quality of life during the final weeks of home hospice care.

A recent survey found that the financial burden of cancer treatment leads many patients to make potentially harmful medical care and lifestyle tradeoffs.

The FDA has approved combined netupitant and palonosetron (Akynzeo) for the treatment of chemotherapy-related nausea and vomiting in patients with cancer.

In a policy statement on the relationship between cancer and obesity, ASCO called on oncologists to integrate obesity prevention and management into patient care.

Using a simple questionnaire to assess anxiety in breast cancer patients before surgery may help alleviate patients’ fear and uncertainty, and improve outcomes.

Individualized counseling should begin before surgery and continue throughout treatment for breast cancer survivors fearful of developing lymphedema, says a new study.

Involving palliative care teams early in the disease process in the outpatient setting can significantly improve end-of-life care for cancer patients, a recent study found.

Patient navigators can play an important role in helping poor and underserved women overcome barriers to receiving recommended care for breast cancer, a recent study found.

Researchers have developed a tool to measure patients’ risk for financial toxicity following cancer diagnosis and treatment.

Instituting a patient navigation program may help to aid in the continued cancer care of populations at a higher risk of being lost to follow-up, according to the results of a multicenter study.

The children of patients with cancer may be at a significantly increased risk for mental and behavioral health problems, according to the results of a recent study.

A new guide developed by nurses and patients with gynecologic cancer offers a much-needed practical resource for women struggling to understand the impact of cancer treatment on their sexual health.

Oncologists who participated in communication workshops improved their ability to talk with patients about their prognoses and provide emotional support, a recent study found.

Distress screening programs will soon be a required component of care at cancer centers. Recommendations on the implementation of these programs were recently published.

A survey-based study out of Japan has revealed that more systematic approaches to nursing practices will be required to ensure ongoing patient safety and adherence as it relates to oral chemotherapy.

According to a recent study, 89% of patients would be willing to use hypnosis to control side effects associated with cancer treatment. So, if patient are willing to try this, why are we not utilizing this kind of therapy more often? Myths associated with hypnosis are generally the reason.

Cancer patients who are of reproductive age (especially women) can be a challenge to treat when it comes to fertility, birth control during treatment, and treatment administration during pregnancy. And for women diagnosed with cancer during pregnancy, safe treatment options need to be considered.

With the boom of technological advances and the increased use of social media come the potential ethical issues surrounding patient privacy and confidentiality.

Many of you have heard of stereotactic radiosurgery, but do you have an understanding of what this actually is, what kind of tumors are treated, and its associated side effects?

Expressive writing is a brief and simple intervention that a recent study showed helped to reduce cancer-related symptoms and improved physical functioning in patients with renal cell carcinoma.

The introduction of survivorship care plans for cancer survivors may not be a cost-effective use of scarce health care resources, according to the results of a companion study of a randomized controlled trial.

The use of nurse navigators to assist patients with cancer resulted in improvements in patient experience and a reduction of problems with care, according to the results of a recently published study.

Some patients go through the end of treatment without a hint of emotional distress. But for many others, ending acute treatment becomes an emotional “pothole” on the cancer journey.

Moderate to severe fatigue was prevalent among almost half of patients undergoing active treatment and one-third of cancer survivors, according to a recently published study that measured fatigue.

Providing survivorship care plans to primary care physicians could help to enhance care coordination and boost physician confidence; however, a recent study indicated that only a small number of primary care physicians are receiving these plans from oncologists.

Increased doses of aerobic exercises lasting 50 to 60 minutes were found to be more effective than a standard dose of 30 minutes for managing declines in physical functioning and symptoms such as pain, hot flashes, and fatigue in women undergoing chemotherapy for breast cancer.

The results of a recent study indicated that teenagers with parents who have invasive cancer displayed no greater prevalence of psychosocial problems than did their peers with cancer-free parents.

Asking patients to track their nausea and vomiting after a course of chemotherapy helped the health care team to adjust medications and achieve better control of symptoms, according to the results of a small single center study.

A study on screening colonoscopy for colorectal cancers, originally presented at ASCO 2013, found that from 1976 to 2009 late-stage cancer incidence decreased from 117 to 74 cases per 100,000 people, and early-stage incidence decreased from 77 to 68 cases per 100,000.

At ONS Congress 2013, Peggy Scott explains how chemotherapy education classes at The Emily Couric Cancer Center, now in place for 2 years, have put patients at the center of their care and prepared them to start treatment (abstract 129532).

The use of a centralized nurse-led telephone-based care coordination system failed to improve outcomes including quality of life, unmet supportive needs or visits to the emergency department after surgical resection of colorectal cancer, according to the results of a new study.

At ONS Congress 2013, Rebekah Clark discusses a standardized fertility-preservation education program that boosted nurse-patient discussion of fertility options from 0 to 71% and referrals for interested patients from 17% to 80% (abstract 95960).

At ONS Congress 2013, Janet Gordils-Perez, Carla Schaefer, and Jacquelyn Lauria from CINJ discuss evidence-based tools developed to support nursing assessment and effective interventions for patients with sleep-wake disturbances (abstract 120187).

Being offered a brief, dedicated discussion of end-of-life decisions relatively early in the trajectory of advanced cancer led to an earlier placement of do-not-resuscitate orders and decreased the likelihood that patients died in a hospital, a new study showed.

At ONS Congress 2013, Bruce Grant explains how integrating a nurse-driven tobacco cessation program for newly diagnosed oncology patients, called Quit Smart, into regularly scheduled appointments boosted the long-term quit rate (abstract 136806).

Patients who received a prescription for a lethal dose of secobarbital as part of a Death with Dignity program qualitatively described being grateful for the prescription, whether or not it was used, according to a recent study.

The use of a yoga program helped to reduce symptoms of insomnia among women with breast cancer undergoing hormonal therapy, and also resulted in an improved quality of life, according to new data presented at ASCO.

Results of a new study indicated that patients with terminal cancer are more likely to have completed a do-not-resuscitate order when they prefer, and believe that their caregiver prefers, comfort at the end of life.

Nurses from a New Jersey cancer center have adapted several key plans from the CDC, ONS, and other societies to create a comprehensive infection-control plan.

In this interview, Laura Zitella will be discussing challenges and considerations for management and prevention of infection in the oncology setting-in both patients with solid tumors and those with hematologic malignancies.

Oncology nurses from a community hospital in Cincinnati, Ohio implemented a two-pronged process for the safe handling of chemotherapy, improving nurses’ satisfaction and comfort levels regarding chemotherapy safety.

A team of nurses and physicians from Huntsman Cancer Institute successfully implemented key changes in their Patient Acute Change Team that increased nurse involvement and reduced the number of codes by 90% in the outpatient setting since they were put in place 2 years ago.

This interview covers standards for healthcare provider competency in offering comprehensive genetic services, and highlights genetics/genomics resources for nurses.

The integration of information technology into healthcare-such as EHRs and patient portals-is growing by leaps and bounds, and cancer care is no exception. Judy Murphy from HHS provides important perspectives on this topic.

In this interview, Tami Borneman, who is presenting a poster at the 38th Annual ONS Congress, will discuss spirituality: what it means, and how spiritual interventions can benefit patients with cancer

February 4 marks World Cancer Day 2013--this year is devoted to dispelling myths about cancer, such as cancer is a death sentence or a disease of the wealthy.

Over 5 million central venous catheters are inserted annually in the United States. Yet the ‘ideal’ access device does not exist. A host of issues preclude optimizing central line care.

Massage is considered a complementary modality in cancer care, used in tandem with medical therapies to promote comfort. The strongest evidence for the use of massage in cancer care suggests its ability to reduce pain and anxiety.

Culture is a tool that its members use to assure their survival and well-being, as well as provide meaning to life. Conflict related to cultural beliefs within healthcare commonly arises during times of significant life change.

Nurses can implement interventions in the workplace to prevent environmental contamination and personal exposure to hazardous drugs.

Genotyping, sometimes referred to as molecular fingerprinting, must be distinguished from genetic testing. Genotyping is done to tumor samples and tests genes in the malignancy only.

With access to clinical trials growing in a variety of clinical settings, nurses increasingly need to develop core skills and knowledge to safely, effectively, and appropriately care for enrolled patients.

In this podcast we discuss integrating palliative care into standard oncology care with Thomas J. Smith, director of palliative medicine at Sidney Kimmel Comprehensive Cancer Center.

A US and European team has developed a 3D technique that produces sharper breast images than those available with standard CT scanners, allowing earlier and more accurate detection of breast tumors.

A large study of the impact of patient navigation (PN) on breast cancer management has found that women who receive PN are diagnosed faster than non-navigated women, and the difference is most striking among biopsied women.

When facing decisions involving children with cancer at the end of life, three themes drove parental decision making--communication, extending time, and understanding prognosis, according to a recent meta-analysis.

In this podcast we discuss the long-term effects of chemotherapy on the cognitive function of cancer patients and the current status of research in this field.

The AICR, noted for its investigation of links between lifestyle and cancer, has released a free digital book for cancer patients and survivors, with current, evidence-based advice on managing diet and activity during and after treatment.

Researchers have concluded after a large meta-analysis of trials involving more than 29,000 patients that patients taking currently available biologic therapies for rheumatoid arthritis (RA) are not at increased risk of cancer.

Highlights from the current literature.

Lung cancer remains the leading cause of cancer death in the United States, with only 16% of patients living 5 years or more after they are diagnosed.

Cancer statistics do not overwhelm me as much as other calculations do. I think this is because I can imagine a human being connected to the rising incidences and changing trends within my chosen specialty.

Chemotherapy is now employed in earlier-stage disease in neoadjuvant, adjuvant, and combined-modality treatments. The aim of this article is to review the current systemic treatments for NSCLC.

Tumor lysis syndrome (TLS) is a potentially life-threatening metabolic disorder characterized by an elevated uric acid level, elevated serum potassium and phosphorus levels, and a decreased calcium level.

The prevention of patient falls is a major healthcare imperative. Falls are associated with avoidable morbidity and mortality, compromised quality of life, and considerable economic burden.

Clinical hypnosis has been defined as a mind-body therapy that involves a deeply relaxed state, individualized mental imagery, and therapeutic suggestion.

Lung cancer remains the number one cancer killer in both men and women, with more deaths attributable to lung cancer than breast, prostate, and colorectal cancers combined.[1]

Vismodegib is for the treatment of adults with metastatic basal cell carcinoma, or locally advanced basal cell carcinoma that has recurred following surgery or who are not candidates for surgery, and who are not candidates for radiation.

Research report from May 2012 ONS Congress interview and poster discussion with Roxann Scheerens, from the Arthur G. James Cancer Hospital and Richard J. Solove Research Institute, Columbus, Ohio.

Research report from May 2012 ONS Congress interview and poster discussion with Deborah Allen, from Duke University.

We’re now entering the fourth decade of HIV/AIDS awareness. Last year marked the 30th anniversary of the earliest report (on June 5, 1981) of what is now known as AIDS (acquired immune deficiency syndrome).

With National HIV Testing Day recently behind us and the 19th International AIDS conference happening later in July in Washington, DC, I would like to share some recent HIV/AIDS statistical, research, and policy highlights.

The FDA has approved a new strategy to evaluate the risk and safety of both extended-release and long-acting opioid analgesic, called a Risk Evaluation and Mitigation Strategy (REMS). The drug class are synthetic versions of opium, that have had a long history of regulated control to mitigate their abuse and illegal distribution.

An intervention aimed at improving diet and exercise among elderly cancer survivors worked well and had durable effects in a new study of more than 600 people.

High levels of certain immunogenomic and inflammatory markers are associated with cancer-related fatigue in some survivors, according to a review of existing literature.

Learn how to help cancer patients and survivors ease into an exercise routine to promote overall wellness and combat fatigue.

Two of every three families in the US will at some time have at least one family member diagnosed with cancer, and family caregivers provide more than 75% of cancer care. Demands on family caregivers are increasing in complexity and duration.

Bao T, Ye X, Skinner J, et al: The analgesic effect of magnetic acupressure in cancer patients undergoing bone marrow aspiration and biopsy: A randomized blinded, controlled trial. J Pain Symptom Manage 41(6):995–1002, 2011. PubMed

Cancer-related fatigue (CRF) in older adults is amenable to resolution by nursing oversight that includes early assessment and the selection of appropriate management approaches. Oncology nurses working with older patient populations at high-risk for CRF should partner with rehabilitation colleagues to create and test exercise interventions that reduce the burden of this common symptom.

Treatment of patients with locally advanced or metastatic non–small-cell lung cancer (NSCLC) that is anaplastic lymphoma kinase (ALK)-positive as detected by an FDA-approved test.

As we ponder our future, it may also be timely not only to look at our personal lives but also to address our professional growth and maturation in a purposeful way.

Leukemias and lymphomas are estimated to contribute up to 7% of all new malignant cases in the United States.[1]

The leukemias and lymphomas represent a group of heterogeneous myeloid or lymphoid clonal stem cell disorders with variable clinical presentation, pathological characteristics, prognosis and recommendations for treatment.[1]

We still have much to do to fully understand the potential of complementary therapies as important elements in cancer treatment and health. Mind-body and body-based interventions may be able to improve health and prevent disease as effectively as pharmacologic agents-without the toxicities associated with pharmacologics, and as adjuncts to pharmacologic therapies they may help to maximize health and diminish disease with less toxicity.

The management of leukemias and lymphomas now includes the use of many targeted therapies. Nurses need to have an understanding of the targeted therapies and their side effects so they can appropriately manage the side effects that their patients with leukemias and lymphomas may experience.

Many cancer patients experience cachexia. In collaboration with an interdisciplinary team including dietitians, oncology nurses are well positioned to implement proactive, multimodality interventions that improve clinical outcomes and quality of life for these patients.

CME Posttest For further information about this activity, and to link to the posttest, please go to: http://www.cmellc.com/CMEActivities/tabid/54/ctl/ActivityController/mid/545/activityid/2390/Default.aspx

A web-based interactive support system tailored for cancer patients reduced patients’ feelings of depression and improved their sense of well being, compared with being given access to resources that are publically available on the internet, results of a large 1-year randomized controlled trial have shown.

A multicenter telephone-interview study has found that cancer patients often perceive that communication problems with healthcare providers have contributed to a breakdown in their care, but very few formally report their concerns.

In a multicenter phase III trial of 360 patients with muscle-invasive bladder cancer, synchronous chemoradiotherapy provided better locoregional control without significant added toxicity, investigators for the Bladder Cancer 2001 trial have found.

Children diagnosed with non-central nervous system cancers at a very young age tend to reach some neurodevelopmental milestones later than healthy children, according to a new study.

Oral nutritional interventions can improve quality of life and overall nutritional intake in some cancer patients, but do not appear to have any effect on mortality outcomes, according to a recent meta-analysis.

Using detailed patient data and mathematical modeling programs, a US–international team of investigators has concluded that in the US, public health efforts beginning in the 1950s prevented nearly 800,000 deaths from lung cancer between 1975 and 2000.

Following a large survey of more than 22,000 US women, researchers from H. Lee Moffitt Cancer Center, in Tampa, Florida, have concluded that a significant proportion of female cancer survivors have poor health behaviors, compared with women who have not had cancer.

Reporting interim findings from a multi-institutional assessment of more than 50,000 people 50 to 69 years of age, COLONPREV Study Group investigators from Spain have concluded colonoscopy is better than fecal immunochemical testing (FIT) at detecting adenomas.

A multi-institutional, NCI-funded retrospective study in the New England Journal of Medicine highlights the significant long-term benefit of colonoscopic polypectomy in preventing death from colon cancer, with polypectomy cutting the incidence of colon cancer–related mortality in half compared with the general population.

The changes in and management of stem cell transplant.

A team of researchers from the University of Connecticut at Storrs and the National Cancer Institute, analyzing US national health data on more than 4,000 racially diverse adults aged 75 years and older, has concluded that despite “ambiguity of recommendations for this group,” cancer screening rates are high in this population.

Epidemiologist Jack Cuzick, PhD, and colleagues, writing in the Journal of the National Cancer Institute in April, concluded that “tamoxifen-induced reductions in breast density can be used to identify women who will benefit the most from prophylactic treatment with this drug.”

Researchers from Wellspring, a Canadian nonprofit organization that supports and educates people with cancer, together with a team of patient-support consultants, have developed a 1-day program that appears to have reduced emotional exhaustion and burnout in oncology nurses.
The often-weakened immune systems of cancer patients receiving chemotherapy put them at greater risk of acquiring life-threatening infections in community and hospital settings, including during appointments for outpatient treatment.

A survey of more than 500 long-term survivors of non-Hodgkin’s lymphoma (NHL) has revealed that more than one-third experience persistent or worsening symptoms of post-traumatic stress disorder (PTSD), with nearly 4 of 10 cancer survivors stating they still experience symptoms of PTSD more than a decade after their cancer diagnosis.

In a Canadian study of more than 14,000 breast cancer survivors over 65 years of age, current use of tamoxifen appears to be associated with a small increased risk of diabetes. The findings do not mean tamoxifen is a direct cause of diabetes in this patient population, the study authors emphasized, but they said its use may increase diabetes risk in older women who already have known risk factors for diabetes, such as obesity or a family history of the disease.

News of note from the current literature.

Conference Calendar for Fall 2011 - Spring 2012

Black B, Herr K, Fine P, et al: The relationship between pain, nonpain symptoms, and quality of life measures in older adults with cancer receiving hospice care. Pain Med 12(6):880–889, 2011.

In September 2011, the US Food and Drug Administration (FDA) approved marketing of the HE4 Test (Fujirebio Diagnostics, Malvern, Pennsylvania) along with the CA-125 test in the Risk of Ovarian Malignancy Algorithm, called ROMA, to determine the likelihood of finding malignancy at surgery in premenopausal or postmenopausal women presenting with an ovarian adnexal mass.

Counseling women at high risk for ovarian and uterine cancer is a complex process, from genetic diagnosisto the management of at-risk women. Rimes andcolleagues have presented these challenging issues, andsuggested ways to manage them, very well.

Vemurafenib is a protein kinase inhibitor that blocks the mutated gene protein BRAFV600E so that the cascade of messages that drive cell division and prevent apoptosis is stopped, resulting in tumor shrinkage.

Coenzyme Q10, or CoQ10, is a naturally occurring, lipid-soluble antioxidant and an essential electron carrier involved in the mitochondrial respiratory chain. In mitochondria, CoQ10 functions as a coenzyme that assists in the oxidative phosphorylation of nutrients, leading to production of cellular adenosine triphosphate (ATP), or energy.

Dying from cancer is predominantly an elder experience. The person with major responsibility to provide care for the ill family member is often the patient’s spouse, who frequently is an older adult.

Nearly 3,000 people died in the 9/11 tragedy 10 years ago. Yet I cannot help but put this fact into the context of one of the most challenging concerns in the field of public health today: cancer.

The National Breast Cancer Awareness Month (NBCAM) organization, which began its campaign in 1984, is a partnership of more than a dozen national professional medical associations, public service organizations, and government agencies that work together year-round to promote awareness of breast cancer, share up-to-date information about the disease, and provide greater access to screening services.

Patient education and counseling are essential in women at increased risk for ovarian and endometrial cancer. Women must be educated regarding the signs, symptoms, and risks associated with these cancers.

Results of the AZURE trial revealed small improvements in disease-free and overall survival when zoledronic acid was used in addition to adjuvant therapy in a subgroup of early-stage breast cancer patients who had been postmenopausal for more than 5 years.

A new study of collaborative oncology practice models showed that the greater use of nonphysician practitioners (NPPs) led to an increase in productivity for the practice and was satisfying for both physicians and the NPPs. This provides one potential solution for the predicted shortage of oncologists in the next decade.

A statewide survey of oncology nurses administering ambulatory chemotherapy found a high rate of self-reported chemotherapy exposure, with nearly one-fifth of nurses surveyed experiencing skin and eye exposure in the last year.

Older patients may fail to consume their medications as prescribed because of faulty memory, a lack of understanding about the treatments they are being given and their importance, or concerns about cost.

Albright HW, Moreno M, Feeley TW, et al: The implications of the 2010 patient protection and affordable care act and the health care and education reconciliation act on cancer care delivery. Cancer 117(8):1564–1574, 2011. Aranda S, Jefford M, Yates P, et al: Impact of a novel nurse-led prechemotherapy education intervention on patient distress, symptom burden, and treatment-related information and support needs: Results from a randomized, controlled trial. Ann Oncol April 6, 2011 (Epub ahead of print). Baldridge KH, Andrasik F: Pain assessment in people with intellectual or developmental disabilities. Am J Nurs 110(12):28–35, 2010. Barton D: Oral agents in cancer treatment: The context for adherence. Semin Oncol Nurs 27(2):104–115, 2011. Beadle G, Mengersen K, Moynihan S, et al: Perceptions of the ethical conduct of cancer trials by oncology nurses. Eur J Cancer Care (Engl) April 19, 2011 (Epub ahead of print). Bergstrom KJ: Assessment and management of fungating wounds. J Wound Ostomy Continence Nurs 38(1):31–37, 2011. [No abstract available.] Carrion IV, Park NS, Lee BS: Hospice use among African Americans, Asians, Hispanics, and whites: Implications for practice. Am J Hospice Palliat Care June 1, 2011 (Epub ahead of print). Chou PL, Lin CC: A pain education programme to improve patient satisfaction with cancer pain management: A randomized control trial. J Clin Nurs 20(13-14):1858–1869, 2011. D'Agostino NM, Penney A, Zebrack B: Providing developmentally appropriate psychosocial care to adolescent and young adult cancer survivors. Cancer 117(10 Suppl):2329–2334, 2011. Dickerson SS, Alqaissi N, Underhill M, et al: Surviving the wait: Defining support while awaiting breast cancer surgery. J Adv Nurs 67(7):1468–1479, 2011. Doorenbos AZ, Kundu A, Eaton LH, et al: Enhancing access to cancer education for rural healthcare providers via telehealth. J Cancer Educ February 20, 2011 (Epub ahead of print). Edmonds K, Hull D, Spencer-Shaw A: Strategies for assessing and managing the adverse events of sorafenib and other targeted therapies in the treatment of renal cell and hepatocellular carcinoma: Recommendations from a European nursing task force. Eur J Oncol Nurs June 2, 2011 (Epub ahead of print). Eggert J: The biology of cancer: What do oncology nurses really need to know? Semin Oncol Nurs 27(1):3–12, 2011. Ferrell B, Koczywas M, Grannis F, et al: Palliative care in lung cancer. Surg Clin North Am 91(2):403–417, 2011. Fitch MI: Screening for distress: A role for oncology nurses. Curr Opin Oncol 23(4):331–337, 2011. Grant MS, Wiegland DL: Palliative care online: A pilot study on a pancreatic cancer website. J Palliat Med 14(7):846–851, 2011. Harrison SE, Watson EK, Ward AM, et al: Primary health and supportive care needs of long-term cancer survivors: A questionnaire survey. J Clin Oncol 29(15):2091–2098, 2011. Hawley P, Barwich D, Kirk L: Implementation of the Victoria Bowel Performance Scale. J Pain Sympt Manage May 25, 2011 (Epub ahead of print). Head BA, Keeney C, Studts JL, et al: Feasability and acceptance of a telehealth intervention to promote symptom management during treatment for head and neck cancer. J Support Oncol 9(1):e1–e11, 2011. Johnson JR, Ning YM, Farrell A, et al: Accelerated approval of oncology products: The food and drug administration experience. J Natl Cancer Inst 103(8):636–644, 2011. Kamimura A, Schneider K, Lee CS, et al: Practice environments of nurses in ambulatory oncology settings: A thematic analysis. Cancer Nurs March 2, 2011 (Epub ahead of print). Klastersky J, Awada A, Paesmans M, et al: Febrile neutropenia: A critical review of the initial management. Crit Rev Oncol Hematol 78(3):185–194, 2011. Kohler BA, Ward E, McCarthy BJ, et al: Annual report to the nation on the status of cancer, 1975–2007, featuring tumors of the brain and other nervous system. J Natl Cancer Inst 103(9):714–736, 2011. Kolins JA, Zbylut C, McCollom S, et al: Hematopoietic stem cell transplantation in children. Crit Care Nurs Clin North Am 23(2):349–376, 2011.Kopterides P, Liberopoulos P, Ilias I, et al: General prognostic scores in outcome prediction for cancer patients admitted to the intensive care unit. Am J Crit Care 20(1):56–66, 2011. Langford DJ, Tripathy D, Paul SM, et al: Trajectories of pain and analgesics in oncology outpatients with metastatic bone pain. J Pain 12(4):495–507, 2011. Lehto R, Therrien B: Death concerns among individuals newly diagnosed with lung cancer. Death Stud 34(10):931–946, 2010. Lester J, Bernhard L, Ryan-Wenger N: A self-report instrument that describes urogenital atrophy symptoms in breast cancer survivors. Western J Nursing Res December 22, 2010 (Epub ahead of print). Lin MF, Hsieh YJ, Hsu YY, et al: A randomized controlled trial of the effect of music therapy and verbal relaxation on chemotherapy-induced anxiety. J Clin Nurs 20(7-8):988–999, 2011. Linsky A, Nyambose J, Battaglia TA: Lifestype behaviors in Massachusetts adult cancer survivors. J Cancer Surviv 5(1):27–34, 2011. Liu YC, Su PY, Chen CH, et al: Facing death, facing self: Nursing students' emotional reactions during an experiential workshop on life-and-death issues. J Clin Nurs 20(5-6):856–863, 2011. Lopez V, Copp G, Brunton L, et al: Symptom experience in patients with gynecological cancers: The development of symptom clusters through patient narratives. J Support Oncol 9(2):64–71, 2011. Lyman GH: Venous thromboembolism in the patient with cancer: Focus on burden of disease and benefits of thromboprophylaxis. Cancer 117(7):1334–1349, 2011. Mao JJ, Palmer CS, Healy KE, et al: Complementary and alternative medicine use among cancer survivors: A population-based study. J Cancer Surviv 5(1):8–17, 2011. Mayer DK, Travers D, Wyss A, et al: Why do patients with cancer visit emergency departments? Results of a 2008 population study in North Carolina. J Clin Oncol29(19):2683–2688, 2011. McCorkle R, Ercolano E, Lazenby M, et al: Self-management: Enabling and empowering patients living with cancer as a chronic illness. CA Cancer J Clin 61(1):50–62, 2011. McCorkle R: Interdisciplinary collaboration in the pursuit of science to improve psychosocial cancer care. Psychooncology 20(5):538–537, 2011. McQuestion M: Evidence-based skin care management in radiation therapy: Clinical update. Semin Oncol Nurs 27(2):e1–e17, 2011. Meraviglia MG, Stuifbergen A: Health-promoting behaviors of low income cancer survivors. Clin Nurse Spec 25(3):118–124, 2011. Nieder C, Spanne O, Mehta MP, et al: Presentation, patterns of care, and survival in patients with brain metastases. Cancer 117(11):2505–2512, 2011. Nogai H, Dorken B, Lenz G: Pathogenesis of non-Hodgkin's lymphoma. J Clin Oncol 29(14):1803–1811. Norlyk A, Harder I: Recovering at home: Participating in a fast-track colon cancer surgery programme. Nursing Inq 18(2):165–173, 2011. Oh HS, Seo WS: Systematic review and meta-analysis of the correlates of cancer-related fatigue. Worldviews Evid Based Nurs February 22, 2011 (Epub ahead of print). Potter P, Eisenberg S, Cain KC, et al: Orange interventions for symptoms associated with dimethyl sulfoxide during stem cell reinfusions: A feasibility study. Cancer Nurs March 2, 2011 (Epub ahead of print). Shi Q, Smith TG, Michonski JD, et al: Symptom burden in cancer survivors 1 year after diagnosis. Cancer 117(2):2779–2790, 2011. Sussman J, Howell D, Bainbridge D, et al: The impact of specialized oncology nursing on patient supportive care outcomes. J Psychosocial Oncol 29(3):286–307, 2011. Syrjala KL, Artherholt SB, Kurland BF, et al: Prospective neurocognitive function over 5 years after allogeneic hematopoietic cell transplantation for cancer survivors compared with matched controls at 5 years. J Clin Oncol 29(17):2397–2404, 2011. Teuffel O, Amir E, Alibhai S: Cost effectiveness of outpatient treatment for febrile neutropenia in adult cancer patients. Brit J Cancer 104(9):1377–1383, 2011. Trip K, Boloorchi A, Berman H: Utilizing the Canadian Emergency Department Triage and Acuity Scale (CTAS) in an oncology unit urgent care clinic: The university health network experience. Can Oncol Nurs J 21(1):52–57, 2011. Twomey J: Ethical, legal, psychosocial and cultural implications of genomics for oncology nurses. Semin Oncol Nurs 27(1):54–63, 2011. Whitmer K, Pruemer J, Wilhelm C, et al: Development of an outpatient oncology symptom management clinic. Clin J Oncol Nurs 15(2):175–179, 2011. Williams PD, Williams K, Lafaver-Roling S, et al: An intervention to manage patient-reported symptoms during cancer treatment. Clin J Oncol Nurs 15(3):253–258, 2011. Winters-Stone KM, Dobek J, Nail L, et al: Strength training stops bone loss and builds muscle in postmenopausal breast cancer survivors: A randomized, controlled trial. Breast Cancer Res Treat 127(2):447–456, 2011.

Progress in the care of mCRC has occurred relatively rapidly, but current methods of management have placed a significant economic burden on the healthcare system.

I was struck by the recent Jane Brody column in The New York Times entitled “Law on End-of-Life Care Rankles Doctors.”

Invasive aspergillosis is a major cause of life-threatening infection in immunocompromised patients. Nurses are well positioned to identify, educate, and monitor patients at high risk.

Acupuncture is a therapeutic modality in Traditional Chinese Medicine (TCM), developed over the millennia. Treatment involves the placement of needles at selected points on the body, followed by manipulation with physical forces, heat, or, in modern times, electrical stimuli.

Ipilimumab blocks cytotoxic T-lymphocyte antigen 4 (CTLA-4) and theoretically enables cytotoxic T cells to more effectively attack melanoma cells.

Advances in the multidisciplinary management of metastatic colorectal cancer have improved survival considerably, and nurses are key to optimal patient care.

Bellury LM, Ellington L, Beck SL, et al: Elderly cancer survivorship: An integrative review and conceptual framework. Eur J Oncol Nurs 15(3):233–242, 2011.Derby S: Assessment and management of delirium in the older adult with cancer. Clin J Oncol Nurs 15(3):247–250, 2011.Holtslander LF, Bally JM, Steeves ML: Walking a fine line: An exploration of the experience of finding balance for older persons bereaved after caregiving for a spouse with advanced cancer. Eur J Oncol Nurs 15(3):254–259, 2011. Kahana B, Kahana E, Deimling G, et al: Determinants of altered life perspectives among older-adult long term cancer survivors. Cancer Nurs 34(3):209–218, 2011. Pieters HC, Heilemann MV, Grant M, et al: Older women's reflections on accessing care across their breast cancer trajectory: Navigating beyond the triple barriers. Oncol Nurs Forum 38(2):175–184, 2011. Swinney JE, Dobal MT: Older African American women's beliefs, attitudes, and behaviors about breast cancer. Res Gerontol Nurs 4(1): 9–18, 2011. Van Cleave JH, Egleston BL, McCorkle R: Factors affecting recovery of functional status in older adults after cancer surgery. J Am Geriatr Soc 59(1):34–43, 2011.

Oncology nurses are on the frontline of telephone triage. Optimizing telephone interactions with patients is key to improving ambulatory nursing practice, as it allows nurses to efficiently provide symptom management; patient education; emotional support; and high-quality, complete documentation for comprehensive and consistent patient care.

More cancer patients are able to receive chemotherapy, including both oral and intravenous agents, in the home setting. Clearly, the option to self-administer therapy in the absence of an oncology nurse or other healthcare provider poses a potential safety risk.

Melanie Bone, MD, was not yet 40 years old and had four young children when she was diagnosed with stage III breast cancer. “Even though I am a doctor and surgeon, I learned firsthand about the side effects of cancer treatment,” said Dr. Bone, a nutritional gynecologist. “I was too sick to work, so I spent time thinking about how to make the cancer experience easier for future cancer patients.”

A pilot mentor-to-mentor oncology nurse–led training program was developed in which volunteer former patients who have undergone brachytherapy for early stage breast cancer at UCSD were taught by the oncology nurse how to provide information and support to new patients about to undergo the procedure.

Cancer patients undergoing chemotherapy can be very anxious at the initiation of treatment. Cancer center–specific patient education materials that detail what patients can anticipate at each step of the chemotherapy process may alleviate patients’ anxiety and improve their overall experience with chemotherapy.

Human papillomavirus (HPV) is the most common sexually transmitted infection in the United States, with approximately 20 million people currently infected and an additional 6.2 million infected each year, despite increased media attention to HPV as a cause of cervical cancer and the availability of a vaccination to reduce HPV-associated cervical cancer.

One in four Americans facing end-of-life is a veteran. Because of their traumatic experiences during combat, including experiences with death, veterans with cancer and other serious illnesses can have complex healthcare needs.

More cancer patients are able to receive chemotherapy, including both oral and intravenous agents, in the home setting. Clearly, the option to self-administer therapy in the absence of an oncology nurse or other healthcare provider poses a potential safety risk.

Following a retrospective analysis which may be the largest of its kind to date, a multicenter team of investigators says treatment-related hypertension may be a useful biomarker of superior clinical outcome with sunitinib (Sutent) in patients with metastatic renal cell carcinoma (RCC).

An analysis of data from 3,400 men in the large nationwide Prostate Cancer Prevention Trial indicates that, contrary to what might be expected, men with the highest blood percentages of DHA (docosahexaenoic acid), an omega-3 fatty acid commonly found in fatty fish, had 2.5 times the risk of developing aggressive, high-grade prostate cancer, compared with men who had the lowest levels.

A team of researchers has used mass spectrometry to identify a novel six-biomarker serum test that effectively identified lung cancer in never smokers, and which may have other important diagnostic applications in lung cancer.

The US Food and Drug Administration (FDA) has approved a portable noninvasive device, worn on the head, to treat adults whose glioblastoma multiforme (GBM) recurs or progresses following chemotherapy and radiation therapy.

Denosumab is an IgG2 monoclonal antibody that inhibits osteoclastic bone resorption (breakdown) via inhibition of RANKL (receptor activator of nuclear factor-kB ligand).

From the current literature

The recent Centers for Disease Control and Prevention (CDC) report carrying good news about cancer survivorship is an urgent “heads up” for all of us in cancer care. The report states that between the years 1971 and 2001, the number of cancer survivors increased by more than three-fold (from 3 million to nearly 10 million).

Multiple myeloma (myeloma) is a highly treatable disease, but it remains incurable in the majority of cases. It is a heterogeneous disease with variability in its clinical presentation, treatment options, and prognosis.

Ginseng is an herb from the genus Panax of the Araliaceae family that is an important part of traditional Chinese medicine (TCM). It is termed an “adaptogen,” as it is believed to have properties that help to restore balance to the body and protect the body from physiologic stress.

Cognition is a highly sophisticated, multifactorial, interrelated set of neurologic functions responsible for attention, perception, memory, learning, language, and thinking.

Hypersensitivity/infusion reactions can be caused by monoclonal antibodies and chemotherapeutic agents. Immediate interventions are often required.

The study represents one of the largest cancer genomics investigations reported, with more than 10 trillion chemical bases of DNA sequenced. While its results underscore the complexity of breast cancer biology, the mutations uncovered may provide further clues to inform personalized therapy of this common breast cancer subtype.

In July1999, I learned I was pregnant with my son. My sister was pregnant, too, and due to deliver in the fall. I was excited to share my happy news. But my father, then 65, had news of his own: he had been diagnosed with stage III colorectal cancer.

Today, March 8, is the 100th anniversary of International Women’s Day, Here is a small sampling of initiatives by health organizations and healthcare leaders dedicated to treating, preventing, and increasing awareness of women’s cancers, and improving women’s health.

Esophageal cancer generally has a poor prognosis; while preoperative chemotherapy is recommended, tumors often do not respond to treatment.

In a population-based screening study of nearly 20,000 men in Rotterdam, men with baseline prostate-specific antigen (PSA) levels < 3 ng/mL were at very low risk of developing prostate cancer.

Colorectal cancer is one of the most commonly diagnosed cancers in the US, and it is the second leading cause of cancer-related deaths. The risk of developing colorectal cancer increases with age.

An estimated 250 million people globally, and 25 million in the US, suffer from rare diseases. Clearly, because of their low incidence, rare cancers are difficult to study and pose challenges for detection, diagnosis, prognosis, and treatment.

In a study reported in Nature online on February 2, researchers describe a four-gene signature that was more accurate than the standard Gleason score test in predicting which patients would die from metastatic spread of their prostate cancer.

After IV administration, the human plasma protein binding of eribulin at concentrations of 100 ng/mL to 1,000 ng/mL ranges from 49% to 65%, and drug is eliminated (mean elimination half-life) in 40 hours.

ONCOLOGY Nurse Edition Continuing Medical Education February 2011

Falls and the risk of falls are critical health concerns that can impact cancer treatment and recovery. In 2007, the Centers for Disease Control (CDC) reported that more than 18,000 older adults in the United States died from injuries sustained from falls (CDC, 2010).[1] Older people diagnosed with a malignancy and who are undergoing cancer treatment using chemotherapy have an increased risk of falls.[2]

It is my pleasure to start 2011 by adding a new professional responsibility to my résumé, that of Editor-in-Chief of ONCOLOGY Nurse Edition. Although ONCOLOGY Nurse Edition is a relatively new publication, now entering its fifth year, the journal boasts a readership of 15,000 oncology nurses nationwide.

Patient falls are a common cause of morbidity and are the leading cause of injury deaths in adults age 65 years and older. Injuries sustained as result of falls in a cancer hospital are often severe, regardless of patient age, due to the nature of the underlying cancer.

While 90% of cancers occur as a result of factors related to lifestyle, the environment, or aging, 5% to 10% of cancers are passed down from generation to generation. Breast cancer is the most common cancer diagnosis in American women.

One area in which to start is to ensure that colleagues are aware of the 2007 Oncology Nursing Society (ONS) Position Paper on cancer in the elderly.[8] This position paper lays out the landscape of caring for older adults with cancer both in terms of problems to date and future initiatives to address.

Yoga, an ancient tradition that originated approximately 5,000 years ago in Central Asia, is a complete system of mental and physical practices for health and well-being. Predominantly practiced within the philosophical context of Ayurvedic medicine in India, yoga as a mind-body therapy is now also increasingly popular in the West, practiced by approximately 15 million individuals.

Oncology nurses must play an integral role in improving the treatment of breakthrough pain-one patient, one in-service for colleagues, and one clinical research study at a time.

Franklin, Delengowski, and Yeo have made a strong case for the importance of cancer rehabilitation.

The assessment and management of breakthrough pain in patients with cancer is pivotal to comprehensive pain and symptom management, and good cancer care.

The 5-year survival rate of cancer patients in the United States is about 66%, and today there are approximately 12 million cancer survivors in the US.

Mindfulness meditation and other mindfulness-based practices are gaining popularity due to a burgeoning evidence base supporting its benefits for a broad range of conditions and populations, including cancer patients[1] and healthcare professionals.

Current advances in the field of medicine have aided in the early detection and treatment of cancer, leading to an increased rate of survivorship among cancer patients after an initial diagnosis.

Cabazitaxel is a microtubule inhibitor in the taxane class. It is made from a yew needle precursor using a semisynthetic process. It binds to free tubulin, which is used during mitosis to form two daughter cells.

The increasing national and international attention to October as Breast Cancer Awareness Month brings to mind the tremendous progress made by the women’s rights movement over the last few decades.

Mrs. S. is a 37-year-old Caucasian female who sought care at her home institution overseas during a period of several months for complaints of esophageal reflux, constipation, early satiety, increasing abdominal girth, and fatigue.

Through evidence-based clinical practice, research, and patient teaching, nurses play an important role in addressing infection risk, and in managing infections, in patients with cancer.

Energy therapies consist of interventions that are designed to interact with the biofield of a person. The concept of the biofield is based on the assumption that all living things have a natural flow of energy that is integral to their basic composition.

Drug is indicated for the treatment of patients with cutaneous T-cell lymphoma (CTCL) who have received at least one prior systemic therapy.

Early and appropriate management of infection in the patient with cancer is critical to optimizing patient outcomes.

Early detection of cancer and novel chemotherapy agents have resulted in longer survival following a colorectal cancer diagnosis.

Two very different articles in this issue of ONCOLOGY Nurse Edition drive home the lesson that evidence-based practice improves cancer care.

You are a Registered Nurse working in a busy oncology unit. While assessing one of your patients, you notice that the bag of morphine used in his patient-controlled analgesia (PCA) system is running low.

On February 16, 2010, a Risk Evaluation and Mitigation Strategies (REMS) program to ensure safe use of erythropoiesis-stimulating agents (ESAs) was approved by the US Food and Drug Administration (FDA).

The May 2010 theme of Oncology Nursing Month is “Oncology Nurses: There When You Need Us.”

When she learned that she had breast cancer, Patricia Garrett did what many people with cancer do: she continued working.

More than 2.5 million breast cancer survivors live in the US today.[1] This number will continue to grow thanks to early detection and advances in treatment that are making early stage breast cancer an increasingly curable disease.

Approved Drugs: Pazopanib (Votrient) Indications

With about 12 million cancer survivors living in the US,[1] cancer affects millions of working Americans. Improvements in early detection and treatment have resulted in a significant number of newly diagnosed and long-term survivors of working age.

Curcumin is yellow curry powder, also called turmeric, Indian saffron, “Haldi,” or “curry powder.” It is a yellow pigment present in turmeric and constitutes 2%–5% of turmeric.

The patient, “TB,” is a 44-year-old Caucasian, married woman with three daughters, 21, 18, and 10 years of age.

An estimated 219,440 new cases of lung cancer were expected in 2009, accounting for about 15% of cancer diagnoses.

Chemotherapy-induced peripheral neuropathy (CIPN) is one of the most challenging and complex complications of cancer chemotherapy.

None; investigational agents olaparib (AZD2281) and BSI-201 are in phase I and II clinical trials; other PARP inhibitors under investigation include AGO 14699 (Pfizer), ABT-888 (Enzo), and MK4827 (Merck).

Lea and Calzone have provided an outstanding overview of genetics and genomic research applicable to the subspecialty of oncology nursing.

Owing to the success of today’s cancer treatments, many cancer survivors are now living through and beyond the cancer experience.

As a new decade unfolds, we are very fortunate to have an increasing number of new interventions available because of the recent tremendous advances in genetics and genomics.

At least half of all Americans are at risk for consequences resulting from low health literacy

Ginger, the rhizome of Zingiber officinale Roscoe, is best known for its role as a flavoring agent for food in Asian and Indian recipes.

Cognitive impairment, including memory loss, inability to concentrate, and difficulty multitasking, has become a widely recognized possible late effect of chemotherapy and cancer treatment.

Genetic and genomic research is creating new and more individualized approaches to better manage a person's disease or predisposition to disease, including cancer.

There has been a growing recognition in recent years that young adults with cancer are a distinct demographic group with unique needs, issues, and challenges related to their age and developmental stage of life.

Ms. Hydzik's article on intraperitoneal chemotherapy (IPC) for the treatment of ovarian cancer provides the rationale for IPC, presents the supporting evidence, and describes nursing management of these patients through the Memorial Sloan-Kettering Cancer Center experience.

In July 2009, the US Food and Drug Administration (FDA) granted approval for use of the vascular endothelial growth factor (VEGF) inhibitor bevacizumab (Avastin) in combination with interferon alfa for treatment of patients with metastatic renal cell carcinoma (RCC).

Ovarian cancer is the most deadly gynecologic malignancy. In the US alone, an estimated 21,500 new cases will be diagnosed in 2009, and an estimated 14,600 women will die from this disease.

For young adult survivors, coming to terms with a life-threatening illness is a unique dilemma.

The US Food and Drug Administration's Office of Oncology Drug Products has announced class labeling changes to product labels for the anti-EGFR

As oncology nurses, we increasingly encounter issues related to integrative medicine in our community practices, clinics, and hospitals.

Vitamin D-the so-called “sunshine vitamin”-is a fat-soluble substance and is classified more as a pro-hormone or steroid by some

Hypothyroidism is a common and potentially serious endocrine disorder in the general population.

October marks National Breast Cancer Awareness month, now in its 25th year, a time to contemplate important advances and milestones as well as future research needs.

In the US, breast cancer is the most common invasive cancer in women, with more than 200,000 diagnosed with the disease each year.

Melanoma continues to be a poorly understood and frequently under-recognized cancer threat to society. The authors have provided a comprehensive overview of this malignancy from diagnosis to advanced-stage therapy.

Melanoma affects persons of all ages, causing more years of lost life than any other cancer except leukemia.[1] The American Cancer Society estimates that about 68,720 new melanomas will be diagnosed in the US in 2009, with more than 8,650 deaths, and an estimated lifetime risk of 1 in 50 for whites, 1 in 200 for Hispanics, and 1 in 1,000 for blacks.[2]

While many oncology nurses have heard of survivor care plans, their details remain obscure. Ms. Houlihan has presented an excellent composite overview of what survivor care plans entail and the barriers limiting their use.

Once-daily oral inhibitor of mTOR (mammalian target of rapamycin) for the treatment of patients with advanced renal cell carcinoma (RCC) after failure of treatment with sunitinib (Sutent) or sorafenib (Nexavar).

Recognition of the growing number of cancer survivors in the United States, combined with a greater awareness of the ongoing physical and psychosocial needs after cancer treatment, has created a groundswell of interest in designing quality care initiatives for cancer survivors.

Formal recommendations for the support and management of cancer patients who are transitioning from active treatment to long-term follow-up are fairly recent, documented notably in the 2006 Institute of Medicine report, From Cancer Patient to Cancer Survivor: Lost in Transition.

Living life to the fullest is an essential goal for everyone, and cancer survivors deserve no less. Almost 12 million cancer survivors in the US today are living longer and experiencing the long-term consequences of their disease and its treatments. Nurses will be providing much of the care that these survivors will require. The quotation cited in the article by Dr. Haylock articulates the problems of survivors living with advanced cancer. The words “I can’t die yet, I still have frequent flier miles”

Oral mucositis (OM), also referred to as stomatitis, can negatively impact radiation and chemotherapy treatment schedules and add to oncology patients’ emotional and physical distress. About 35% to 40% of patients treated with cytotoxic chemotherapy will develop OM, with higher rates occurring in bone marrow transplant patients.

Cancer-related fatigue is a common side effect during cancer treatment, and research demonstrates that it is a troubling, lingering side effect for many long-term survivors. Long-term cancer survivor fatigue is under-reported, underdiagnosed, and undertreated.[1] Studies suggest that the prevalence of fatigue in breast cancer survivors may be as high as 30%,[2] and that fatigue levels are higher in cancer survivors than in healthy controls,[3] even as long as 5 years after treatment.[1]

Robyn was 63 years old when she was diagnosed with Stage III ovarian cancer. After recovering from a total abdominal hysterectomy and oopherectomy, she traveled to a comprehensive cancer center to consult with a physician specializing in ovarian cancer. She took her entire collection of pathology slides and reports, laboratory and imaging study reports, and the summary of her surgical procedure.

Hypertension (HTN) is prevalent in the general population, particularly in individuals over the age of 60 years. More than 50% of individuals aged 60 to 69 years and more than 75% of individuals age 70 or older are affected.[1]

Bendamustine HCl for injection is FDA approved for treatment of patients with chronic lymphocytic leukemia (CLL) or indolent B-cell non-Hodgkin’s lymphoma (NHL) that has progressed during or within 6 months of treatment with rituximab (Rituxan) or a rituximab-containing regimen.

The patient, “JB,” is a 68-year-old woman who underwent a right lumpectomy and axillary node dissection for stage II breast cancer. Her oncologist suggested adjuvant chemotherapy (four cycles of cyclophosphamide [Cytoxan] at 600 mg/m2 plus doxorubicin [Adriamycin] at 60 mg/m2) followed by local radiation therapy.

When caring for patients with a new cancer diagnosis, oncology nurses generally have clear and distinct plans to assist each patient through the phases of diagnosis and treatment. Nurses provide guidance, support, and well-defined patient education regarding the planned treatment, as well as anticipatory guidance regarding management of side effects and emotional responses to diagnosis and treatment.

One of the potential side effects of chemotherapy is cardiac toxicity. The resulting damage to the heart can range from non–life-threatening events to devastating heart failure. The spectrum of these events can occur almost immediately, during a drug infusion, or as a delayed complication later in the patient’s life. Oncology nurses not only need to be familiar with identifying and intervening in acute cardiac events, but also in some instances will need to monitor for delayed cardiac toxicities during the continuum of the patient’s life.

Hospice care continues to be underutilized. Indeed, owing to untimely referrals, many patients who begin hospice care unfortunately die shortly thereafter, having never received the full benefits provided by hospice. In her excellent article, Dr. Prince-Paul provides a case example that demonstrates the familiar multifaceted issues faced by cancer patients nearing end of life and discusses how hospice care could be of tremendous benefit to the patient, family, and professional.

Ms. D is a 45-year-old woman with ovarian cancer and hepatic metastatic disease. She has received multimodal treatment over the past 5 years. Ms. D lives in her own home, is divorced, and is a single parent of two adolescent children. Her mother is her primary caregiver and also has a deteriorating health condition.

Change is in the air-and I don’t just mean the arrival of spring. The current national focus on health care is clearly evident from many quarters, including policy makers, health care institutions, and clinical staff. In addition to the discussion on health care coverage, there is an increasing emphasis on patient-centered care. As a result, we have before us a unique opportunity to assure the inclusion of survivorship and end-of-life care as formal parts of the health care continuum.

The patient, "JD," is a 62-year-old Caucasian female who had stage IV non–small cell lung cancer (NSCLC) diagnosed 3 months ago. Her medical history is significant for chronic obstructive pulmonary disease (COPD). She quit smoking cigarettes more than 6 months ago after having smoked a pack per day for 40 years.

The cytochrome P450 microenzyme system has been an important protective system for living things for at least 3 billion years. It is a group or superfamily of isoenzymes that live in the endoplasmic reticulum and mitochondrial membrane of cells, and initially were responsible for detoxifying any poisons that were inhaled or ingested. As a result, these enzymes are found in the nose, saliva, kidneys, and lungs, and in greater numbers in the small intestines and liver. Cytochrome P450s account for about 75% of total metabolism and are important in oxidative metabolism-chemical modification/degradation of drugs.

In their informative article, Richard O’Hara and Diane Blum touch on several key challenges of cancer survivorship. Looking at cancer through the lens of social concerns and developmental issues, they have brought important psychosocial aspects of survivorship to the forefront of our attention, with a particular focus on the domain of social well-being within the parameters of interpersonal relationships, and financial, employment, insurance, and legal issues.

When my doctor told me that I would have to put my life on hold at age 25 because tests confirmed that I had Hodgkin’s disease-cancer!-my life changed totally. I had to quit my job, move back in with my parents, and wonder about the quantity and quality of the rest of my life.

It is estimated that more than 62,000 men and women will be diagnosed with melanoma in 2008, with more than 8,400 deaths, and an estimated lifetime risk predicted to be 1 in 55.[1] Although deadly in its later stages, melanoma carries an excellent prognosis if it is diagnosed early. Fortunately, most melanoma cases (80%) are diagnosed at a localized stage; the 5-year survival rate for this group is 98.5%.

Bill, 53 years old and a 3-year survivor of non-Hodgkin’s lymphoma, reflects on his ongoing journey as a cancer survivor: “I was very sick and treatment was very rough, complete with a severe allergic reaction that was difficult to diagnose for a long time. But I made it through to the other shore…remission. Since then, I’ve been trying to rebuild a new life…Living with an 18-year-old [son], I can see how in some ways I’m in a parallel universe…Both of us are looking out at the world before us, at all the many possible options...trying to figure out what we want tomorrow to look like.

As difficult as treatments are for many cancer patients, another difficult time awaits them at the conclusion of therapy. Until that point, patients have become accustomed to the fleeting comfort of regularly scheduled appointments for diagnostic testing, chemotherapy and/or radiation treatments, and ongoing contact with health care professionals. Conclusion of treatment can seem abrupt and the absence of attention can be unsettling for many. It is at this point that patients often ask, “What can I do now to help myself?”

In 2008, roughly 1.44 million Americans were diagnosed with cancer,[1] and accordingly were labeled as “cancer survivors.” Fortunately, for roughly 65% of those who were newly diagnosed, this label will expand to encompass issues of long-term survivorship and health maintenance.[2] Extended cancer survivorship is a relatively new concept. In the past, most people who were diagnosed with the disease did not survive it. While longer survival times are a measure of success, the dark side of this victory is that a substantial proportion of these survivors will experience recurrence or second cancers. In addition, many more will go on to develop comorbid conditions such as cardiovascular disease (CVD), diabetes, or osteoporosis, which often kill or debilitate survivors at much higher rates than the cancer itself.[3,4]

Osteoporosis, the most common late effect of cancer treatment in the US, occurs with greater frequency among cancer survivors than the general population. Survivors of breast cancer, prostate cancer, and childhood leukemia are at particularly high risk for changes in bone mineral density (BMD) / osteoporosis that can lead to fractures.[1] In breast and prostate cancer patients, bone effects are often the result of endocrine therapy–induced alterations in bone microarchitecture. They also can be caused by other types of cancer therapy, vitamin D deficiency, and other physiological changes that may or may not be related to cancer or its treatment. In childhood leukemia patients, bone effects can be caused by a variety of factors, including corticosteroid therapy, radiation therapy to the brain, and the disease itself.

When you have cancer, you can get diarrhea for a number of reasons. Most often, it is a side effect of treatments, such as chemotherapy or radiation therapy.

Cancer occurs in approximately 1 per 1,000 pregnancies. For the woman and her family, the diagnosis creates an emotional upheaval of hopes and fears and raises the issue of immortality and mortality simultaneously. The treatment proposed to save the mother can appear in direct conflict with the desire to protect the developing fetus.

A diagnosis of cancer and its subsequent treatment can be a very frightening and confusing experience for the pregnant patient, and are challenging for the physician and nurse. As women delay childbirth until later in life, the incidence of pregnancy associated with cancer is expected to increase. Currently, approximately 1 in 1,000 pregnancies is complicated by cancer.[1–5]

When you have cancer, constipation is more likely to occur because of the cancer itself or as a side effect of treatment. If you have constipation, your doctor or nurse can help you to treat it and prevent it in the future.

42-year-old Caucasian female who was in her usual state of health when her first mammogram showed suspicious calcifications and a spiculated mass in the upper outer quadrant of the right breast. An ultrasound-guided biopsy showed an invasive ductal carcinoma. She underwent a lumpectomy, with the excised tumor measuring 1.2 cm. The tumor was estrogen and progesterone positive and HER2/neu negative.

Gina, age 9, and Rosemary, age 66. They had different cancers, but developed similar skin ulcers over their entire bodies. Gina's wounds were open to air for 4 weeks. Her pain was severe. Two weeks after starting wound care, Gina allowed us to take pictures of her wounds. We promised to teach doctors and nurses how to care for her wounds. Unfortunately, Gina died. The pictures were lost. A year later, Rosemary was admitted with a similar skin condition and allowed us to photograph the progression of her wound care. Our promise to Gina is now kept. Here we describe the wound care plan necessary to relieve the pain and discomfort of partial-thickness wounds from dermatological conditions in oncology patients.

With perhaps 100 patients scheduled for chemotherapy each day and about the same number of consultations, the nurses, physicians, and staff in any medium-sized oncology clinic are fully booked. Changing their routines may be the last thing anyone wants to think about.

Diabetes mellitus is a frequent comorbidity of cancer patients. The growing epidemic of diabetes is anticipated to have tremendous impact on health care. Diabetes may negatively impact both cancer risk and outcomes of treatment. Oncology nurses are ideally positioned to identify patients at risk for complications that arise from cancer treatment in the setting of pre-existing diabetes. Additionally, oncology nurses may be the first to identify underlying hyperglycemia/hidden diabetes in a patient undergoing cancer treatment. Strategies for assessment and treatment will be discussed, along with specific strategies for managing hyperglycemia, potential renal toxicity, and peripheral neuropathy. Guidelines for aggressive treatment of hyperglycemia to minimize risks of complications will be reviewed. The role of interdisciplinary care, utilizing current evidence, is crucial to supporting patients and their families as they manage the challenges of facing two life-limiting diseases. Whole-person assessment and individualized treatment plans are key to maximizing quality of life for patients with cancer and diabetes.

FDA-Approved Drugs: 5-HT3 receptor antagonists Zofran (ondansetron), Kytril (granisetron), Anzamet (dolasetron), Aloxi (palonosetron); NK-1 receptor antagonist: Aprepitant (Emend)

Cancer clinical trials are a necessary component of the effort to improve cancer prevention, diagnosis, and treatment. Essential to this process is the informed consent of the individuals who participate in these research studies. The purpose of this article is to describe patient, provider, and informed consent process issues with presentations of data reported in the current literature. The role of nursing in the facilitation of informed consent is discussed.

Bisphosphonates are an important part of managing bony metastasis of prostate, breast, lung, and other cancers but can cause osteonecrosis of the jaw (ONJ) in some patients.

Nursing management of patients with advanced malignancies presents a formidable challenge. In addition to the discomfort and debilitation these diseases can cause, side effects of traditional treatment modalities such as surgery, chemotherapy, and radiation may lead to severe and sometimes fatal sequelae. New targeted therapies promise an effective treatment with more easily tolerated and managed side effects. Basic understanding of the drugs' mechanism of action contributes to the successful management of the toxicities that can be manifested. Effective patient education results in improved compliance with treatment regimens and potentially improved clinical outcomes. Nursing intervention remains a vital component in the successful use of these novel agents.

The high prevalence of pain in the cancer population underscores why pain management is integral to comprehensive cancer care. How well pain is controlled can have a profound effect on the cancer experience for both patient and family. The goals of pain assessment are to prevent pain if possible, and to identify pain immediately should it occur. This can be facilitated by standardized screening of all cancer patients for pain, on a routine basis, across care settings. A comprehensive assessment of pain follows if a patient reports pain that is not being adequately managed. Oncology nurses play a huge role in pain assessment and management throughout the course of a patient's disease. A basic understanding of the types of pain seen in the cancer population as well as inferred neurophysiologic pain mechanisms and temporal patterns of pain can help focus the pain assessment. This in turn will lead to targeted pain management strategies

Chemotherapy-induced febrile neutropenia (FN) predisposes patients to life-threatening infections and typically requires hospitalization. The goal was to investigate whether a risk assessment tool aligned with national guidelines could help identify patients at risk of FN and reduce FN-related hospitalizations. Beginning in October 2004, oncology nurses applied the new risk assessment tool to all patients initiating chemotherapy or a new regimen. Patients at risk for FN received prophylactic colony-stimulating factor. Charts for 189 patients receiving chemotherapy in fiscal year 2005 (FY05) were compared with charts of 155 patients receiving chemotherapy in FY04, before the tool was implemented. The incidence of FN-related hospitalization declined by 78%, from 9.7% in FY04 to 2.1% in FY05 (P = .003). Total hospital days decreased from 117 to 24. Routine systematic evaluation by oncology nurses improves recognition of patients at risk of FN and substantially reduces FN-related hospitalization.

Major deficiencies in the management of cancer-related pain are well documented and impact all dimensions of the patient's life, including physical, psychological, social, and spiritual well-being.

With the trend toward the use of oral rather than intravenous therapies for cancer, nonadherence to treatment has become an increasing concern. Advanced practice nurses are in a good position to assess and monitor adherence to oral endocrine therapies. Research on adherence has been limited; to date there are no specific published guidelines for ensuring adherence to endocrine regimens. However, studies have identified many factors that may lead to nonadherence, including demographic, social, and psychological characteristics of the patient; characteristics of the disease and the treatment regimen; and the nature and quality of the patient/clinician relationship. These factors provide a framework that advanced practice nurses can use to identify potential problems and to work collaboratively with patients.

Dr. Ann Berger does an excellent job of writing to the chronic pain sufferer in her book Healing Pain. Health-care providers and family caregivers will also find it an excellent resource and can benefit greatly from reading this work. Throughout the book the author maintains a true sense of hope for the individual experiencing significant pain. Her ability to communicate this sense of hope will be rather contagious for the health-care provider who may have become less than enamored with our ability to accomplish pain management in individuals with complex pain syndromes.

Oncology nurses play a pivotal role in educating the cancer patient who is about to commence oral chemotherapy. Increasing numbers of patients are receiving oral chemotherapy at home, and with this move to oral self-